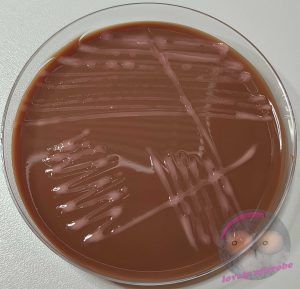
Roseomonas mucosa auf PVX Agar
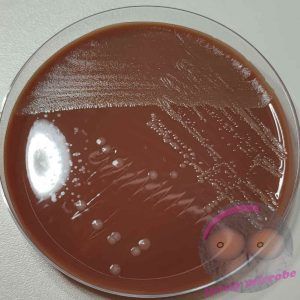
Haemophilus influenzae auf HAEM Agar
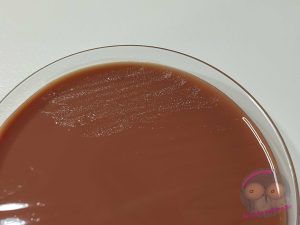
Neisseria gonorrhoeae auf VCA3 Agar

Kochblutagar einfach erklärt: Optimalmedien für anspruchsvolle Erreger
Auch der Kochblutagar (Schokoladenagar) gehört heutzutage zum Standardrepertoire in der
Mikrobiologie.
- Einführung:Mikrobiologie leicht erklärt: Nährmedien, ihre Typen und Anwendungen
- Blutagar einfach erklärt – Aufbau, Hämolyse und Anwendung
- MacConkey Agar erklärt: Selektiv- und Differentialmedium für gramnegative Bakterien
- Kochblutagar einfach erklärt: Optimalmedien für anspruchsvolle Erreger
- CLED Agar in der Urindiagnostik einfach erklärt
Heute tauchen wir in die Welt des Kochblutagars ein, den einige von euch vielleicht auch als Schokoladen oder Chocolate Agar kennen. Seinen ungewöhnlichen Namen verdankt er der braunen Farbe, die ihn unverwechselbar macht. Zu den häufig verwendeten Agarn zählen unter anderem PolyVitex, Haemophilus und Thayer Martin Agar. Wir werfen einen Blick auf ihre Zusammensetzung, entdecken die Gemeinsamkeiten und Unterschiede und erfahren, warum sie in der Mikrobiologie so unverzichtbar sind.
Wer sich vorab einen Überblick über die verschiedenen Nährmedien verschaffen möchte, findet in meinem Artikel „Mikrobiologie leicht erklärt: Nährmedien, ihre Typen und Anwendungen“ eine kompakte Einführung.
Kochblutagar (Schokoladenagar)
Zuerst klären wir, was man ganz allgemein unter einem Kochblutagar versteht, bevor wir uns den einzelnen Nährmedien im Detail widmen. Kochblutagar zählen zu den Optimalnährmedien und werden für das Wachstum sogenannter anspruchsvoller Erreger verwendet, zum Beispiel Neisserien oder Haemophilus Arten.
Allen Kochblutagaren ist gemeinsam, dass das enthaltene Blut kurz auf etwa 80°C erhitzt wird. Durch dieses Erhitzen werden die Erythrozyten aufgelöst und zwei wichtige Wachstumsstoffe freigesetzt: Nikotinamidadenindinukleotid, auch NAD oder Faktor V genannt, und Haemin, das als Faktor X bekannt ist. Auf diese Weise koennen auch Bakterien, die selbst keine Hämolyse auslösen können, diese beiden Stoffe aufnehmen und verarbeiten.
Hämin
Hämin ist eine komplexe Verbindung aus einer Häm Gruppe und einem Eisen Ion in der Oxidationsstufe drei. Ein Chlorid Ion dient als axialer Ligand und stabilisiert diese Struktur.
NAD
NAD, also Nicotinamidadenindinukleotid, ist ein weiteres wichtiges Molekül, das im Agar zur Verfügung steht. Es handelt sich um ein Coenzym, das formal ein Hydrid Ion überträgt, also zwei Elektronen und ein Proton. NAD spielt eine entscheidende Rolle in zahlreichen Redoxreaktionen des zellulären Stoffwechsels. Viele anspruchsvolle Bakterien sind auf diesen Stoff angewiesen, weil sie ihn nicht selbst in ausreichender Menge bilden können.
Die typische braune Farbe des Agars entsteht übrigens auch durch das Erhitzen und verleiht ihm den bekannten Namen Schokoladenagar.
Die genaue Zusammensetzung kann je nach Hersteller leicht abweichen, doch im Kern bestehen alle Kochblutagar aus den gleichen Grundbestandteilen. Zu den gängigen Bestandteilen eines Nährmediums werden zusätzlich noch Vitamine, spezielle Aminosäuren und Phosphate (Puffer zum Erhalt des pH Wertes) hinzugefügt um das Wachstum der anspruchsvollen Erreger zu unterstützen.
Zusammensetzung
- Zusammensetzung
- Agar
- Pankreatisch abgebautes Casein
- Fleischpepton
- NAD
- Hämin
- Phosphate
- spezielle Aminosäuren
- Vitamine
Polyvitex (PVX) Agar
Der PVX Agar ist der einfachste der drei Kochblutagar, die ich euch heute vorstelle. Er besteht im Grunde aus den bereits genannten Bestandteilen. Bei den Platten von biomerieux wird PolyVitex als Mischung der beiden Faktoren X und V beschrieben, also Hämin und NAD.
Im Unterschied dazu enthält die Anreicherung IsoVitaleX zum Beispiel von der Firma BD noch weitere Komponenten wie Vitamine, Aminosäuren, Coenzyme, Dextrose und Eisen Drei Ionen. Dadurch wirkt IsoVitaleX insgesamt breiter unterstützend für anspruchsvolle Erreger, während PolyVitex sich auf die beiden zentralen Wachstumsfaktoren beschränkt.
Generell wachsen auf diesem Agar insbesondere Haemophilus spp., Neisseria spp. aber auch Pasteurellen und Moraxellen sehr gut.
Haemophilus (HAEM) Agar
Dem Haemophilus Agar werden in der Regel bestimmte Antibiotika und Antimykotika zugesetzt, um die übrige Begleitflora zurückzudrängen und so ein möglichst ungestörtes Wachstum von Haemophilus spp. zu ermöglichen. Häufig verwendet man dafür zum Beispiel Bacitracin, Vancomycin und Amphotericin B.
Bacitracin und Vancomycin sind Antibiotika, die das Wachstum grampositiver Bakterien deutlich einschränken. Amphotericin B ist ein Antimykotikum, das vor allem Hefen und andere Pilze am Wachstum hindert. Auf diese Weise entsteht ein Nährboden, der den empfindlichen Ansprüchen von Haemophilus spp. besonders gut gerecht wird.
Thayer Martin (VCA3) Agar
Der Thayer Martin Agar enthält in der Regel folgende Antibiotika: Colistin, Trimethoprim Lactate und Vancomycin. Colistin wirkt gegen sehr viele gramnegative Stäbchenbaktierien aber auch gegen Meningokokken, Trimethoprim insbesondere gegen Proteus spp. und Vancomycin gegen grampositive Bakterien. Zusätzlich wird meist noch Nystatin gegen Pilzwachstum zugefügt. Somit ergibt sich ein ideales Medium für das Wachstum von Neisseria gonorrhoeae.
Der Thayer Martin Agar enthält in der Regel mehrere Antibiotika, darunter Colistin, Trimethoprim Lactat und Vancomycin. Colistin wirkt gegen viele gramnegative Stäbchenbakterien, aber auch gegen Meningokokken. Trimethoprim richtet sich vor allem gegen Proteus spp., während Vancomycin das Wachstum grampositiver Bakterien hemmt.
Zusätzlich wird häufig Nystatin zugesetzt, um das Wachstum von Pilzen zu verhindern. Auf diese Weise entsteht ein Medium, das ideal auf die Ansprüche von Neisseria gonorrhoeae abgestimmt ist und deren ungestörtes Wachstum ermöglicht.
Fazit
Kochblutagar, egal ob PVX, Haemophilus Agar oder Thayer Martin Agar, zeigt uns eindrücklich, wie präzise die Bedingungen sein müssen, damit anspruchsvolle Mikroorganismen gedeihen können. Hinter den scheinbar einfachen Platten verbirgt sich eine komplexe Welt aus Wachstumsfaktoren, selektiven Zusätzen und feinen Abstimmungen. Für mich bedeutet das nicht nur ein tieferes Verständnis der Mikrobiologie, sondern auch eine ästhetische Freude daran, wie sich Wissenschaft und Ordnung auf so kleine Strukturen konzentrieren.
Mehr über den Umgang mit gramnegativen Erregern und deren zunehmende Resistenz findest du in meinem Artikel „Antibiotikaresistenzen„.
Und wenn du noch mehr Lust auf Mikrobiologie bekommen hast, dann schau dir doch mal mein tolles Quizbuch an.